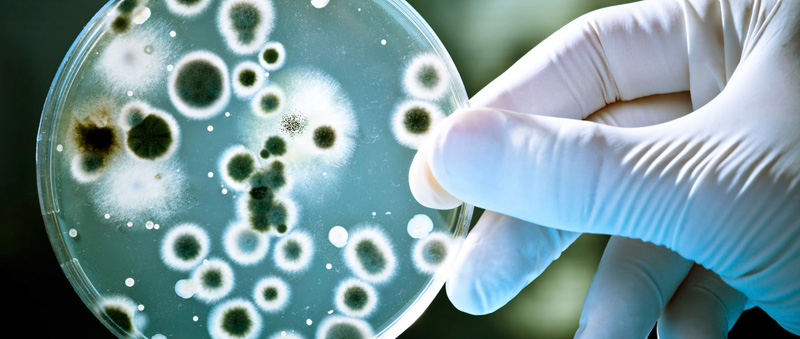

¿Cuántas tazas de café son recomendables?

La cantidad recomendable de café en el organismo no es poca, lo que es (sin duda) una buena noticia
Un asteroide pasará muy cerca de la Tierra la próxima semana

El asteroide pasará a algo menos de 5 millones de kilómetros o el equivalente a 13 veces la distancia entre la Tierra y la Luna
Detectan nueva enfermedad sexual que carcome los genitales
La ‘klebsiella granulomatis’ provoca úlceras sangrantes que terminan por necrosar la carne de los genitales.
El México que dejamos es mejor que el de hace 6 años: Peña Nieto

El mandatario dijo que en los próximos 12 días compartirá sus experiencias en el Gobierno.
Busca Bimbo adueñarse del nombre ‘manteconchas’

Las internacionalmente famosas manteconchas, que son un híbrido entre una mantecada y una concha, fue una creación original de Josué Rivera
La primera línea de maquillaje para hombres está aquí

La línea de maquillaje, Boy de Chanel, estará disponible en todo el mundo a partir de noviembre
Funda Margarita su asociación política

No es un partido pero entérate de lo que pretende hacer la excandidata a la Presidencia de México con esta nueva organización…
En calma elecciones en el Sindicato de Ferrocarrileros sección 34

Se elegirá al secretario general local y al dirigente a nivel nacional.
Sedena Tampico abrirá sus puertas al público mañana

El 15 avo Batallón de Infantería invitó a las familias a que acudan desde las 8 de la mañana y hasta las 12 del día
Victorense es campeón con Pachuca

El defensor victorense fue titular en esta final que se disputó en el Estadio Nemesio Die